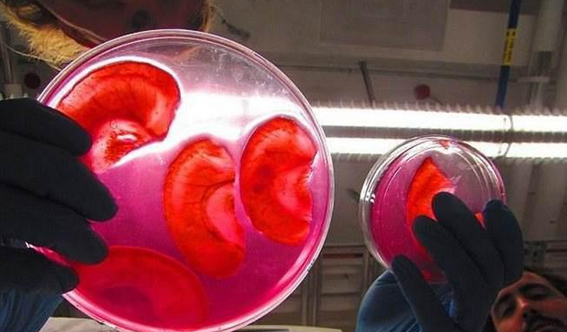

★公众号:寰宇科学(点击复制)微信
听起来就觉得毛骨悚然!用苹果培育出来的真人耳!
2016-7-18 寰宇科学

多年来,科学家从干细胞中培育器官,传统的方法都是尽量取自动物、人体或专有材料,但这个方法是比较复杂和昂贵的。一位加拿大科学家日前突破了这个传统,他的实验团队用苹果作为细胞培养基,培育出了人的“耳朵”,将有助于解决器官短缺。
安德鲁-佩林(Andrew Pelling)是来自加拿大渥太华大学的一位“生物学先锋”,最近他发表了一篇惊人的论文并在TED进行公开演讲,解释如何利用苹果来种植人体器官。
这个听起来令人毛骨悚然的念头是源自于佩林的实验室成员想要从叶片分离出纤维素支架,但叶片表面上有一蜡质涂层,很难分离。一天他偶然看到另一个实验室成员吃苹果,他灵机一动,决定用苹果来代替。
研究人员先提取及分离苹果内的细胞,并将苹果的脱氧核糖核酸移除,仅剩下用来维持植物形状和质感的纤维素支架。
起初这些过程都是使用普通的苹果。其后,佩林的妻子帮他把苹果雕刻成人类耳朵的形状。这些“耳朵”之后被带回实验室让科学家处理,把苹果细胞转为人类细胞。植入人类细胞后,让它们进行四星期的细胞增生。这个方法同样可以培育出肝脏、心脏或皮肤专用的干细胞。

而这些耳朵,真的是人类的耳朵吗?他们能听到声音吗?答案仍然有待研究。不过可以确定的这些耳朵是由真真正正的活的人类细胞组成的,但将这些细胞组合在一起的东西却是苹果纤维素。而该实验室还在寻找其他的农产品,如芦笋,去帮助修复脊髓损伤。

共有491阅 / 0评我要评论
发表你的评论吧返回顶部
!评论内容需包含中文
